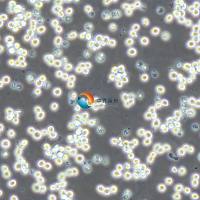
NB4人急性早幼粒白血病细胞

相关产品推荐更多 >
万千商家帮你免费找货
0 人在求购买到急需产品
- 详细信息
- 文献和实验
- 技术资料
- 英文名:
SHZ-88
- 库存:
大量
- 供应商:
中乔新舟
- 细胞类型:
细胞系
- 品系:
rat
- 组织来源:
rat
- 相关疾病:
否
- 物种来源:
rat
- 免疫类型:
否
- 细胞形态:
咨询销售
- 器官来源:
rat
- 运输方式:
T25瓶运输
- 年限:
5-10年
- 生长状态:
贴壁生长
- 规格:
5 x 10^5 cells/vial
|
产品名称 |
SHZ-88大鼠乳腺癌细胞 |
|
货号 |
ZQ0104 |
|
产品介绍 |
这株细胞源自DMBA诱导的大鼠乳房癌。 大多数细胞是上皮细胞样的,也可以见到巨大细胞团和病态有丝分裂;电镜下可见细胞表面和桥粒上有微丝。 第3天的有丝分裂指数是59%。 移植到同源动物中可以成活。 |
|
种属 |
大鼠 |
|
组织来源 |
乳腺 |
|
形态学 |
上皮细胞样 |
|
细胞类型 |
癌细胞系 |
|
换液频率 |
2-3次/周 |
|
生长方式 |
贴壁 |
|
培养基和添加剂 |
90%RPMI-1640(中乔新舟 货号:ZQ-200)+10%胎牛血清(中乔新舟 货号:ZQ500-A)+1%双抗(中乔新舟 货号:CSP006) |
|
推荐完全培养基货号 |
ZM0104 |
|
生物安全等级 |
BSL-1 |
|
培养条件 |
95%空气,5%二氧化碳;37℃ |
|
保藏机构 |
CLS;305209 |
|
供应限制 |
仅供科研使用 |
上海中乔新舟生物科技有限公司成立于2011年,历经十多年发展,主要专注于细胞生物学产品的研究和开发,专注于为药企、各类科研机构及CRO企业提供符合标准规范的细胞培养服务、细胞培养基、细胞检测试剂盒、细胞培养试剂,胎牛血清和细胞生物学技术服务等。
公司一直致力于为高等院校、研究机构、医院、CRO及CDMO企业提供细胞培养完整解决方案,这些产品旨在满足细胞培养的多样需求,确保实验和研究的有效进行。引用中乔新舟(ZQXZBIO)产品和服务的文献超数千篇。

产品服务
细胞资源:原代细胞、细胞株、干细胞、示踪细胞、耐药株细胞、永生化细胞等基因工程细胞。
试剂产品:胎牛血清、完全培养基(适用于原代细胞及细胞株)、无血清培养基、基础培养基、细胞转染试剂、重组因子、胰酶和双抗等等细胞培养所有实验相关产品。
技术服务:稳转株构建、原代细胞分离、特殊培养基定制服务、细胞检测等。

目前产品已经畅销国内30多个省市,与客户建立长期的合作伙伴关系,共同实现成功。全体员工将不懈努力,继续为科研人员提供优良的产品和服务,致力成为全球细胞培养领域的参与者。

企业愿景
致力于成为国内细胞培养基产业的佼佼者,生物医药领域上游原材料的优良提供商。
企业使命
成长为专业细胞系及原代细胞培养供应商、专业细胞培养基及培养试剂生产商。
企业荣誉


风险提示:丁香通仅作为第三方平台,为商家信息发布提供平台空间。用户咨询产品时请注意保护个人信息及财产安全,合理判断,谨慎选购商品,商家和用户对交易行为负责。对于医疗器械类产品,请先查证核实企业经营资质和医疗器械产品注册证情况。
文献和实验
PubMed=19450234; DOI=10.2144/000113089
Rahbari R., Sheahan T., Modes V., Collier P., Macfarlane C.M., Badge R.M.
A novel L1 retrotransposon marker for HeLa cell line identification.
BioTechniques 46:277-284(2009)
PubMed=19722756; DOI=10.5858/133.9.1463
Lucey B.P., Nelson-Rees W.A., Hutchins G.M.
Henrietta Lacks, HeLa cells, and cell culture contamination.
Arch. Pathol. Lab. Med. 133:1463-1467(2009)
Saos-2 TCHu114 人 成骨肉瘤细胞 1000元 SCaBER TCHu 76 人 膀胱鳞癌细胞 400元 SGC-7901 TCHu 46 人 胃腺癌细胞 400元 SHG-44 TCHu 48 人 胶质瘤细胞 400元 SH-SY5Y TCHu 97 人 神经母细胞瘤细胞 800元SHZ-88 TCR 5 大鼠 乳腺癌细胞 400元 SiHa TCHu113 人 宫颈癌细胞 1000元 SK-BR-3 TCHu 49
肝癌细胞 SHZ-88 乳腺癌细胞 CBRH-7919 肝癌细胞 PC-12 肾上腺嗜铬细胞瘤细胞 C6 胶质瘤细胞 RBL-2H3 白血病细胞 3、人类 A-431 表皮癌细胞 HeLa 229 宫颈癌细胞 Tca-8113 舌鳞癌细胞 HCC 94 [HCC941122] 子宫鳞癌细胞(高分化) Acc
浅析染色质免疫沉淀(ChIP)技术在 DNA 与蛋白质相互作用研究中的重要性
或者尚不能得出确切结论,因此需要 ChIP 试验进行有力的支持。有研究 [6] 通过 WB, MSP,EMSA 等技术发现乳腺癌细胞的高度恶性与抑制肿瘤转移相关的 TFPI-2 基因启动子区过度甲基化有关,之后用 ChIP 试验则证实了该区域高度甲基化后确实转录水平因此受到影响,为上述的结论提供更充分的论据。类似的,Peng 等人 [13] 用 EMSA 技术得出水稻转录因子 OsLFL1 结合于 Ehd1 基因的启动子区的初步结论后,采用 ChIP 在体内重复出了这个结果,因此最终能确定该转录
技术资料暂无技术资料 索取技术资料